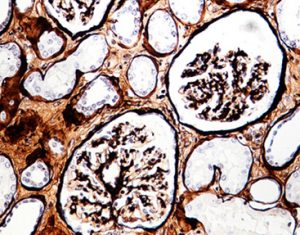

The Periodic Acid-Silver Metheramine Staining method is of great diagnostic value for observing various morphological changes of the glomerular mesangium and basement membrane. It could not be replaced by other special staining method, especially for observing the formation of the nail of the substrate membrane in the membranous nephropathy and the double or multi-track changes of the amyloidosis nephropathy basement membrane.
Meanwhile,it is also sensitive to all kind of fungal stains and easy to be found even there is a small amount of fungi. It can clearly present that the basement membrane in nephropathy ,mostly to be utilized for observing the glomerular capillary basement membrane during inflammatory injury such as fracture and hyperplasia , folding and other forms of change.
After the sections were treated with periodic acid water, the polysaccharides in the basement membrane of kidney tissue or the polysaccharides in the fungus in lung tissue were oxidized to expose the aldehyde group. The free aldehyde group reduces the silver ions in the periodic acid-silver metheramine solution to metallic silver and appears black. The gold chloride transforms metallic silver intro more stable metallic gold while making the background clearer. Sodium thiosulfate fixes the colored silver salt and removes unreacted silver ions. Hematoxylin staining counterstains the cell nucleus to show blue, the overall staining is bright and the background is clean.
a)Greatly shorten the short staining time, silver staining can be completed in 15-20min
b)No silver mirror reaction; clean slide
c)Bright staining
d)No precipitates and insoluble substances in each component reagent; stable
e)Hematoxylin is not affected by storage temperature. After low temperature or freezing, there is no sediment and does not affect the color of staining.
|
Name |
Storage |
|
|
Solution A: Periodic acid aqueous solution |
2-8 ℃ avoid light |
|
|
periodic acid-silver metheramine working solution (B) |
B1: methenamine, borax |
2-8 ℃ avoid light |
|
B2: silver nitrate solution |
2-8 ℃ avoid light |
|
|
Before use the same amount of B1 and B2 should be mixed, that is the hexaamine silver working fluid; ready to use |
||
|
Solution C: gold chloride solution |
2-8 ℃ avoid light |
|
|
Solution D: hypo solution |
2-8 ℃ avoid light |
|
|
Solution E: hematoxylin solution |
2-8 ℃ avoid light |
|
The glomerular basement membrane is black, and hematoxylin, eosin, bright green, or aniline blue can be used for counterstaining